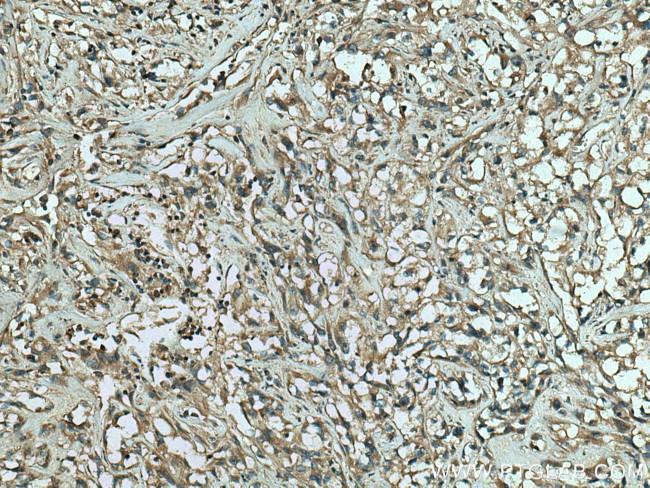
RAB25 Antibody in Immunohistochemistry (Paraffin) (IHC (P))

Search
Proteintech
RAB25 Polyclonal Antibody
{{$productOrderCtrl.translations['antibody.pdp.commerceCard.promotion.promotions']}}
{{$productOrderCtrl.translations['antibody.pdp.commerceCard.promotion.viewpromo']}}
{{$productOrderCtrl.translations['antibody.pdp.commerceCard.promotion.promocode']}}: {{promo.promoCode}} {{promo.promoTitle}} {{promo.promoDescription}}. {{$productOrderCtrl.translations['antibody.pdp.commerceCard.promotion.learnmore']}}
产品信息
13189-1-AP
种属反应
宿主/亚型
分类
类型
抗原
偶联物
形式
浓度
规格
纯化类型
保存液
内含物
保存条件
运输条件
产品详细信息
Immunogen sequence: MGNGTEEDY NFVFKVVLIG ESGVGKTNLL SRFTRNEFSH DSRTTIGVEF STRTVMLGTA AVKAQIWDTA GLERYRAITS AYYRGAVGAL LVFDLTKHQT YAVVERWLKE LYDHAEATIV VMLVGNKSDL SQAREVPTEE ARMFAENNGL LFLETSALDS TNVELAFETV LKEIFAKVSK QRQNSIRTNA ITLGSAQAGQ EPGPGEKRAC CISL (1-213 aa encoded by BC033322)
靶标信息
RAB proteins, such as RAB25, are members of the RAS superfamily of small GTPases that are involved in membrane trafficking. Members of the RAB11 subfamily, including RAB25, control the return of internalized membrane-associated moieties to the cell surface.
仅用于科研。不用于诊断过程。未经明确授权不得转售。
生物信息学
蛋白别名: CATX-8; Ras-related protein Rab-25
基因别名: CATX-8; CATX8; RAB11C; RAB25
UniProt ID: (Human) P57735
Entrez Gene ID: (Human) 57111